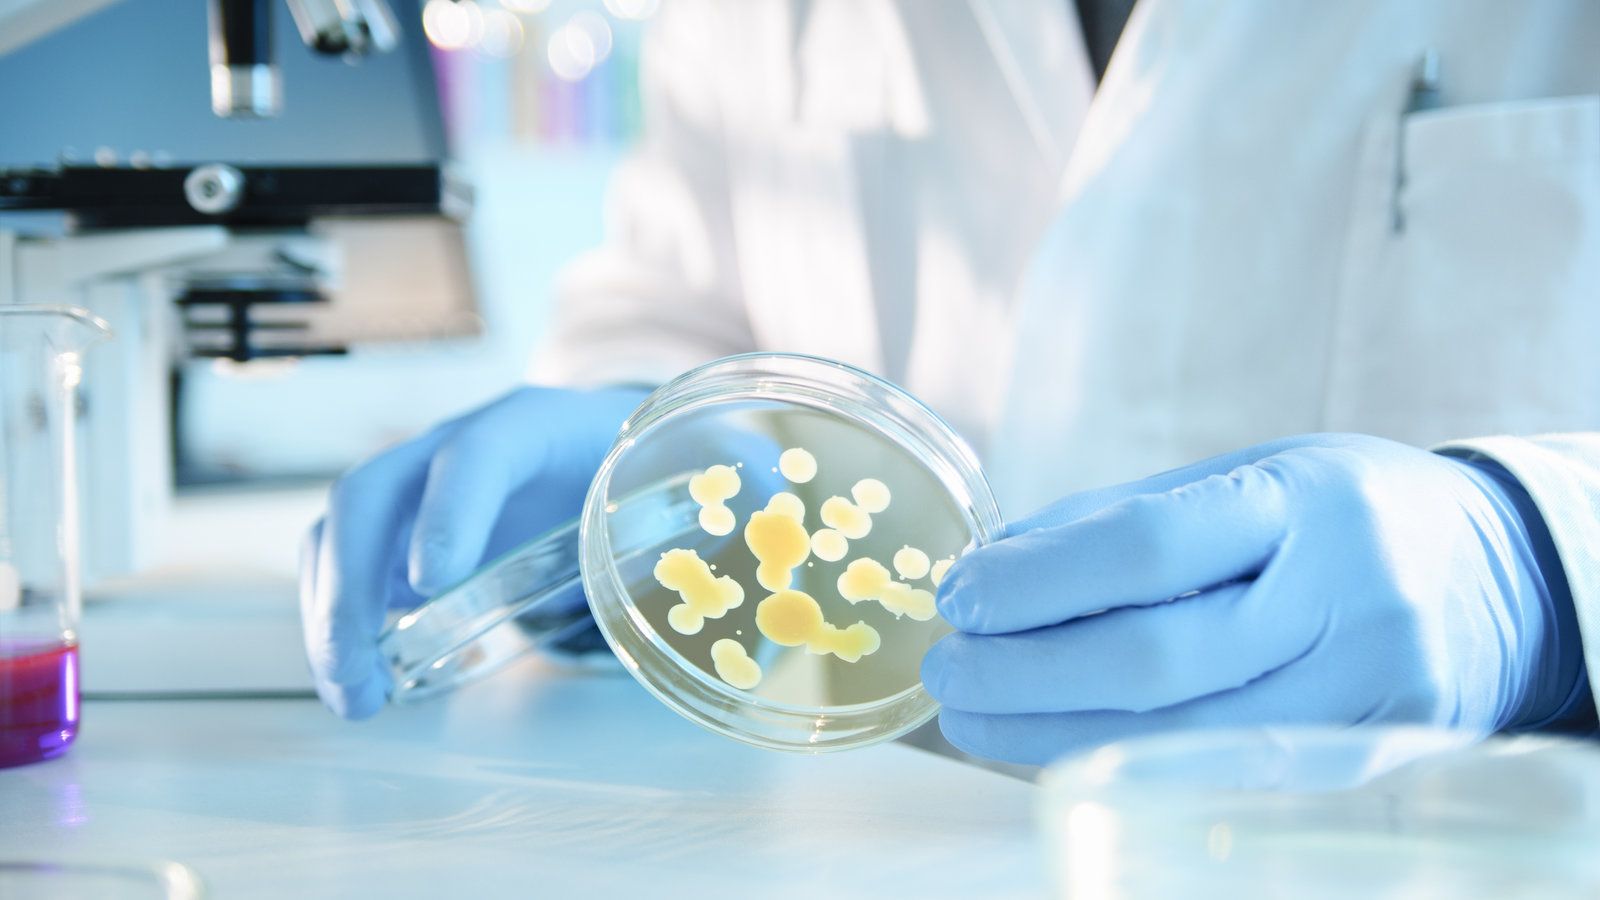
Fondo de pantalla de  1600x900
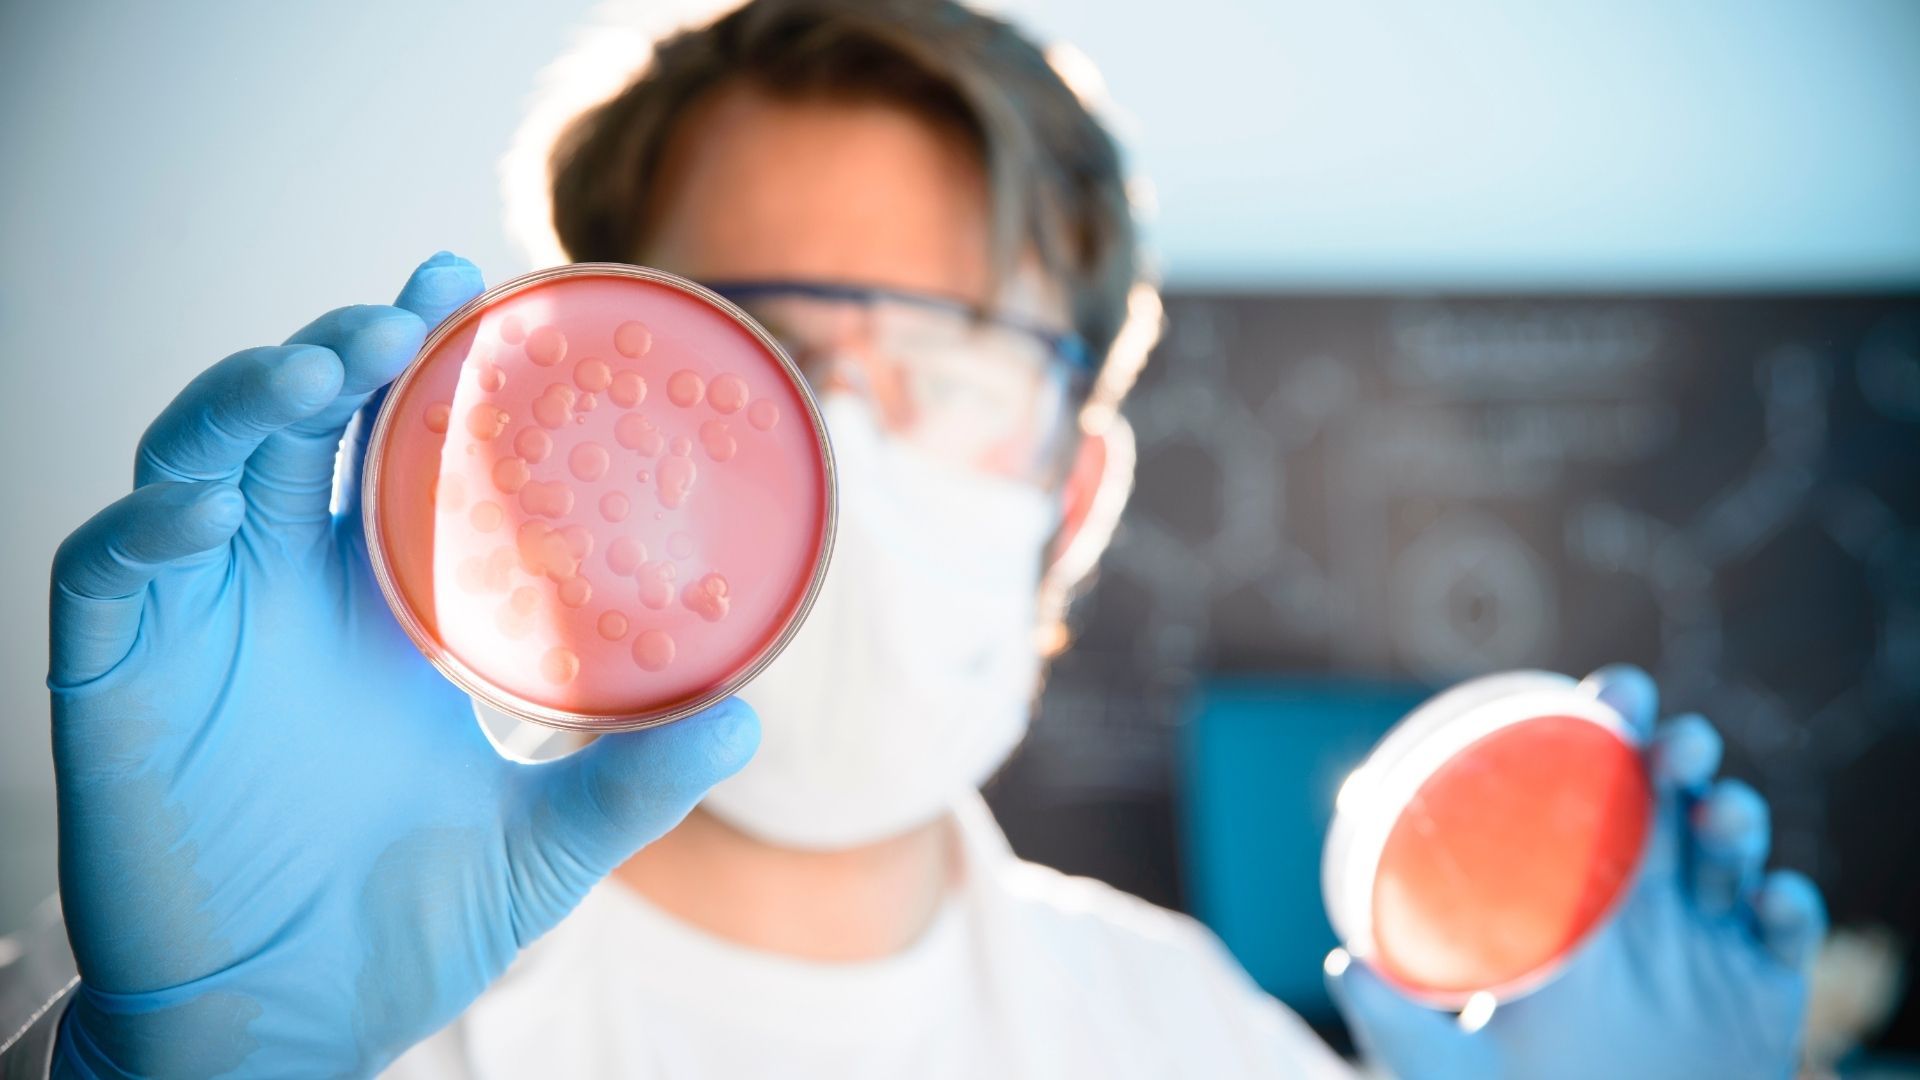
Fondo de pantalla de  1920x1080

Descargar fondo
Fondos de pantalla de microbiología
¡Los mejores fondos de microbiología gratis para descargar!
Disfruta de los siguientes 43 fondos de pantalla de microbiología para tu móvil o escritorio.
Ver más fondos de Naturaleza.